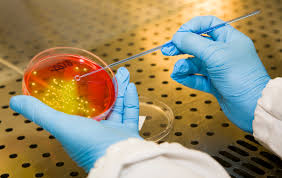

Biotecnologie Agrarie
classe di Laurea (LM -7 R) di nuova Istituzione
La seconda finestra immatricolazioni è aperta fino al 31 marzo 2026 – inizio delle lezioni 02.03.2026

Biotecnologie Agrarie
classe di Laurea (LM -7 R) di nuova Istituzione
La seconda finestra immatricolazioni è aperta fino al 31 marzo 2026 – inizio delle lezioni 02.03.2026


Biologia Cellulare Molecolare e Ricerca Biomedica
Classe di Laurea LM-6 R

attività di Laboratorio

























































agg.03.02.2026

Quanto costa iscriversi (sito di Ateneo)
Utilità e Servizi allo studente
Come Iscriversi a Tor Vergata
Descrizione e obiettivi formativi
Il corso forma laureati con una elevata preparazione professionale nei vari campi delle Biotecnologie industriali; le competenze in biochimica, biologia molecolare, genetica, farmacologia e microbiologia sono arricchite con aspetti di ecologia, economia, sviluppo etico.
Gli studenti apprendono e approfondiscono le metodologie di studio e di sviluppo dei sistemi biomolecolari e dei bioprocessi fondamentali per l’impiego delle biotecnologie nel mondo della ricerca, dell’industria e dei servizi. Studiano modificazioni genetiche, produzione di proteine, farmacologia, tecniche di produzione e controllo dei cibi.
Gli studenti completano la formazione con attività di laboratorio e tirocinio (24 CFU), affiancati da esperti del settore, sviluppando importanti competenze tecniche che ne favoriscono l’assorbimento nel mondo del lavoro.
This Degrees trains graduates with high vocational skills in a number of Biotechnology fields. Expertise in Biochemistry, Molecular Biology, Genetics, Pharmacology and Microbiology is enhanced with notions of Ecology, Economics and Ethical Development.
Students learn and deepen study and development methods on bio-molecular systems and bio-processes critical to the use of Biotechnology in research, industry and services. They study genetic modifications, protein production, pharmacology, techniques of food production and control.
Students complete their training with laboratories and internship activities (24 ECTS) supported by industry experts and hence developing important technical skills that will favour their work placement.

agg.03.052.2026

Iscrizioni Aperte WELCOME GUIDE 2025/2026
Quanto costa iscriversi (sito di Ateneo)
Utilità e Servizi allo studente
Come Iscriversi a Tor Vergata
Descrizione e obiettivi formativi
Il corso si rivolge a laureati di varia provenienza (Biologia, Dietistica, Medicina e Chirurgia, Farmacia), e fornisce conoscenze interdisciplinari sulle caratteristiche degli alimenti e il loro effetto sullo stato di salute, sia da punto di vista del contenuto in nutrienti, che da quello della sicurezza igienica.
I laureati magistrali devono conoscere i principali parametri della biochimica e della biochimica e biologia molecolare clinica, collegati con il fabbisogno e il metabolismo dei nutrienti e dei non nutrienti fisiologicamente attivi, nonché utili per la valutazione dello stato nutrizionale. Devono acquisire solide conoscenza sull’organizzazione cellulare e sulla classificazione degli organismi viventi, anche sulla base delle teorie evolutive. Devono inoltre conoscere la relazione fra nutrienti e modulazione dell’assetto genico e del proteoma, nonché gli effetti sul metabolismo cellulare di inquinanti industriali e additivi alimentari.
Nell’ambito delle discipline della nutrizione umana, i laureati magistrali devono conoscere le tecniche di valutazione dello stato nutrizionale, i concetti di dieta bilanciata e di fabbisogno nutrizionale, oltre agli effetti metabolici delle diete ipocaloriche più diffuse. Devono inoltre conoscere il meccanismo d’ azione e l’interazione dei farmaci con i nutrienti, l’impatto delle malattie legate alla malnutrizione sulla sanità pubblica. Devono essere anche a conoscenza degli aspetti fisio-patologici che riguardano l’apparato digerente.
Nell’area tecnologica e della gestione agroalimentare, i laureati devono conoscere la composizione degli alimenti, nonché le tecniche più avanzate per la lavorazione e la conservazione del cibo, oltre agli eventi di trasformazione chimica indotti dalla cottura e alle malattie da microrganismi trasmesse dagli animali domestici e dal terreno e causate dalle loro tossine diffuse nelle derrate alimentari.I laureati devono inoltre essere a conoscenza degli aspetti economici, sociali e legislativi che permettono la formazione di una figura professionale (Nutrizionista) capace di intervenire nei diversi campi affrontati dalla moderna scienza dell’alimentazione e nutrizione umana.
Numero di posti programmato a livello locale – Classe LM-61 R (D.M. 270/2004
Lingua: Italiano


Chimica
classe di Laurea LM-54 R














































